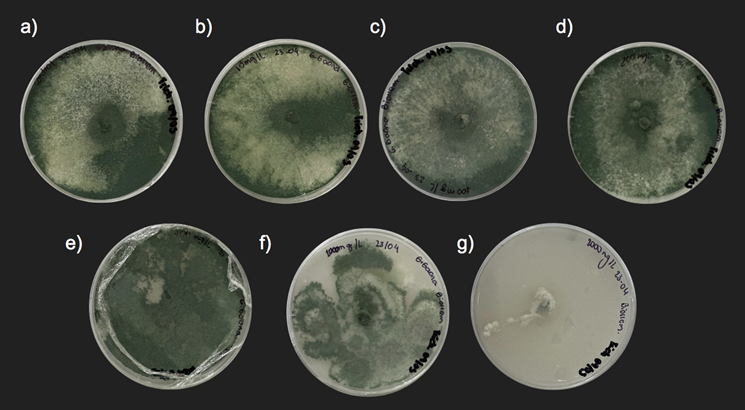

10.18004/rdgic.Investig.estud.UNA.2025.junio.2916014634
Ciencias Naturales ǀ ARTÍCULO ORIGINAL

*Autor correspondiente:
gabrielggaona@gmail.com
Editor de área:
María
Dolores Rey
, Universidad de
Córdoba, España
Editora jefe:
Griselda
A. Meza Ocampos
, Universidad
Nacional de Asunción (UNA). Centro Multidisciplinario de Investigaciones Tecnológicas
(CEMIT). San Lorenzo, Paraguay.
Co-editora:
Juliana
Moura Mendes Arrúa
, Universidad
Nacional de Asunción (UNA). Centro Multidisciplinario de Investigaciones
Tecnológicas (CEMIT). San Lorenzo, Paraguay.
Recibido:
31 de agosto de 2024
Revisado:
14 de octubre de 2024
Aceptado:
29 de enero de 2025
Recibido en versión modificada:
06 de abril de 2025
Este
es un artículo publicado en acceso abierto bajo una Licencia Creative Commons “CC BY 4.0”. ![]()
Declaración de conflicto: Los autores declaran no tener conflicto de intereses.
e-ISSN 2709 -0817
Como citar: Gaona Duarte, V. G., Coronel Cristaldo, R. N., Solalinde Ramírez, N., Patiño Santander, J., Galeano Amarilla, A. F., Ovelar Maldonado, A. y Benítez, G. A. (2025). Crecimiento y tolerancia de Trichoderma asperelloides TF5 en medio papa dextrosa agar (PDA) a distintas concentraciones de cipermetrina Revista investigaciones y estudios – UNA, 16(1), pp. 4-14.
Crecimiento y tolerancia de Trichoderma asperelloides TF5 en medio papa dextrosa agar (PDA) a distintas concentraciones de cipermetrina
Growth and tolerance of Trichoderma asperelloides TF5 in potato dextrose agar (PDA) at different concentrations of cypermethrin
Vicente
Gabriel Gaona Duarte1, 2*
, Rocío de las Nieves Coronel Cristaldo1
, Nicole Solalinde Ramírez1
, Jana Patiño Santander1
, Ana Flavia Galeano Amarilla1
, Anabel Ovelar Maldonado1
, Gilberto Antonio Benitez1,2![]()
1 Universidad Nacional de Asunción. Facultad de Ciencias Exactas y Naturales. Departamento de Biotecnología. San Lorenzo, Paraguay.
2 Universidad Nacional de Asunción. Centro Multidisciplinario de Investigaciones Científicas y Tecnológicas. San Lorenzo, Paraguay.
Resumen. El uso continuo y excesivo de insecticidas piretroides ha generado numerosos problemas ambientales y de salud pública, por lo que su eliminación del medio ambiente es un tema de interés. Los recursos biológicos como microorganismos o enzimas, con capacidad de degradar o eliminar plaguicidas, se han convertido en una herramienta poderosa para la remediación de los ambientes contaminados con estos compuestos, considerando esto, el objetivo de este trabajo fue evaluar la tolerancia de Trichoderma asperelloides TF5 a distintas concentraciones de cipermetrina, con el fin de analizar su potencial para ser utilizado en biorremediación. Para la realización del estudio, se utilizó un medio de cultivo sólido (PDA) papa dextrosa agar con concentraciones de cipermetrina de 10, 100, 200, 500, 1000 y 2000 mg/L. Se evaluó el crecimiento micelial y el porcentaje de inhibición del crecimiento de Trichoderma en función de las diferentes concentraciones. Los resultados demostraron, a partir de un gráfico de regresión lineal, que el 50% de inhibición del crecimiento micelial se alcanza con una concentración de 1150 mg/L, comparable a la utilizada en campo. Por lo tanto, Trichoderma asperelloides TF5, debido a su tolerancia evidenciada, muestra un potencial prometedor para su aplicación en procesos de biorremediación.
Palabras clave: insecticida, piretroide, tolerancia, biorremediación, micorremediación.
Abstract. The continuous and excessive use of pyrethroid insecticides has generated numerous environmental and public health problems, making their removal from the environment a topic of interest. Biological resources such as microorganisms or enzymes, with the ability to degrade or eliminate pesticides, have become a powerful tool for the remediation of environments contaminated with these compounds. The objective of this research was to evaluate the tolerance of Trichoderma asperelloides TF5 to various concentrations of cypermethrin and to analyze its potential for use in bioremediation. For the study, a solid culture medium (PDA) with cypermethrin concentrations of 10, 100, 200, 500, 1000, and 2000 mg/L was used. Mycelial growth and the percentage of growth inhibition of Trichoderma were evaluated as a function of the different concentrations. The results demonstrated, based on a linear regression graph, that 50% inhibition of mycelial growth is achieved with a concentration of 1150 mg/L, a concentration comparable to that used in the field. Therefore, Trichoderma asperelloides TF5, due to its demonstrated tolerance, shows promising potential for application in bioremediation processes.
Keywords: insecticide, pyrethroid, tolerance, bioremediation, mycoremediation.
Introducción
Los plaguicidas, considerados contaminantes orgánicos persistentes, generan preocupación por su presencia y efectos adversos en diversos ecosistemas. A pesar de que los residuos de pesticidas pueden degradarse mediante procesos físicos, químicos y bioquímicos, su alta estabilidad y solubilidad en agua permiten su persistencia en el medio ambiente (Odukkathil y Vasudevan, 2013). En Paraguay, la agricultura se ha convertido en la base para el desarrollo económico, con proyecciones de un incremento del 4,9% en el PIB agrícola para el año 2024 (CAPECO, 2024). Este crecimiento implica la utilización de grandes extensiones de terreno y el uso intensivo de defensivos agrícolas, algunos de los cuales presentan características ecotoxicológicas con potenciales efectos negativos en el medio ambiente (López Arias et al., 2021).
Entre los plaguicidas más utilizados destacan dos grupos principales: los organofosforados, empleados tanto en aplicaciones agrícolas como domiciliarias, y los piretroides, compuestos sintéticos derivados de la piretrina natural que han ganado popularidad en la agricultura en las últimas décadas debido a su eficacia (Gajendiran y Abraham, 2018). Sin embargo, el uso continuo y excesivo de los piretroides ha generado preocupación por sus impactos ambientales y en la salud pública, ya que se ha demostrado que pueden causar toxicidad reproductiva, neurotoxicidad y alteraciones en el sistema hormonal (Chen et al., 2011; Kaur y Singh, 2021).
La cipermetrina es un insecticida de amplio espectro que se utiliza ampliamente para el control de plagas en cultivos agrícolas y entornos domésticos. A pesar de su eficacia, sus residuos pueden tener un impacto negativo significativo en el medio ambiente y los organismos vivos (Kaur y Singh, 2021). La cipermetrina presenta una toxicidad alta para peces e invertebrados en concentraciones tan bajas como 10μg/L (Lin et al., 2011).
La eliminación de plaguicidas del medio ambiente es un tema de interés para los investigadores hoy en día. Durante los últimos años, el uso de recursos biológicos para degradar o eliminar pesticidas se ha convertido en una poderosa herramienta para su degradación y remediación. Entre los recursos biológicos, los hongos se han caracterizado y aplicado ampliamente para la biodegradación y biorremediación de plaguicidas, entre los cuales se encuentra la cipermetrina (Maqbool et al., 2016).
Dentro de los hongos se encuentra el género Trichoderma, este hongo se destaca por su capacidad de adaptarse y producir diversos metabolitos de interés biotecnológico y ambiental, como enzimas y compuestos promotores del crecimiento vegetal. Este hongo se emplea como agente de biocontrol contra hongos fitopatógenos gracias a su versatilidad metabólica y a sus múltiples mecanismos de acción. Además, Trichoderma es capaz de degradar una amplia gama de biomasa vegetal y compuestos más complejos, incluyendo plaguicidas, lo que sugiere su potencial en la biorremediación de estos productos químicos (Hernández-Melchor et al., 2019). La habilidad de Trichoderma para degradar plaguicidas se atribuye a su capacidad para producir enzimas hidrolíticas (Tripathi et al., 2013; Ríos et al., 2019).
Por esta razón, el presente trabajo de investigación se enfocó en evaluar la tolerancia de una cepa nativa de Trichoderma asperelloides a distintas concentraciones de cipermetrina de uso comercial, con el fin de analizar su potencial de ser utilizado en biorremediación de suelos contaminados.
Materiales y Métodos
Obtención y activación de la cepa
La cepa de Trichoderma asperelloides TF5 fue cedida para este trabajo por el Mycology Investigation and Safety Team del Centro Multidisciplinario de Investigaciones Tecnológicas (CEMIT) de la Universidad Nacional de Asunción (UNA). La activación de la cepa se llevó a cabo en las instalaciones de la Facultad de Ciencias Exactas y Naturales (FACEN-UNA), la inoculación se realizó tomando un explante de la cepa proveída en medio papa-dextrosa-agar (PDA), la misma se mantuvo a temperatura ambiente (25ºC) durante 7 días.
Insecticida y Medio de Cultivo
Se utilizó el insecticida de uso agrícola Bulltrim® cuyo principio activo es cipermetrina 25%. Este insecticida pertenece al grupo de piretroides, siendo ampliamente utilizado en los cultivos de importancia agrícola.
Para evaluar la tolerancia de Trichoderma se prepararon medios de cultivos PDA y se añadieron diferentes concentraciones de cipermetrina (0, 10, 100, 200, 500, 1000, 2000 mg/L) (Castellanos González et al., 2015). Los medios de cultivo con las diferentes concentraciones fueron distribuidos en placas Petri de 90 x 15 mm. La placa control contenía únicamente el medio PDA sin adición de cipermetrina.
Crecimiento y Tolerancia de Trichoderma asperelloides TF5 a distintas concentraciones de cipermetrina
Se sembraron discos de agar de 5 mm de diámetro con micelio fúngico en placas Petri con las diferentes concentraciones de cipermetrina mencionadas anteriormente. Cada tratamiento fue realizado por duplicado. Las mismas fueron incubadas a 28ºC y el diámetro de las colonias se midió luego de 1, 4 y 7 días de crecimiento. Los valores obtenidos se utilizaron para obtener el porcentaje de inhibición radial de los tratamientos respecto al control, donde se aplicó la fórmula utilizada en (Castellanos González et al., 2015):
![]()
Donde:
X= diámetro en cm de la colonia en la placa control
Y= diámetro en cm de la colonia en la placa tratada
Para obtener la concentración de cipermetrina que inhibe el 50% del crecimiento fúngico se promediaron los porcentajes de inhibición obtenidos del Día 1, 4 y 7 y se calculó utilizando una ecuación lineal obtenida por la recta de la gráfica de regresión lineal (concentración vs. porcentaje de inhibición).
Análisis Estadístico
Los datos de diámetro de crecimiento radial obtenidos de cada tratamiento se sometieron a un análisis de varianza (ANOVA), y una prueba de comparación de medias (Tukey, α=0,05) mediante el programa SPSS versión 21. Los gráficos fueron realizados utilizando el software Excel.
Resultados
La Figura 1 muestra los valores del diámetro promedio de las colonias de Trichoderma asperelloides (cepa TF5) cultivadas en diferentes concentraciones de cipermetrina (0, 10, 100, 200, 500, 1000 y 2000 mg/L) a los días 1, 4 y 7 después de la siembra, bajo condiciones de incubación a 28°C.
En el día 1, se observó crecimiento fúngico en todas las placas tratadas con concentraciones de cipermetrina de hasta 1000 mg/L, excepto en las tratadas con 2000 mg/L. El mayor crecimiento (2,3±0,14 cm de diámetro) se registró en las placas control (0 mg/L de cipermetrina). No se detectaron diferencias significativas en el diámetro promedio de las colonias entre el control y las placas tratadas con 10, 100, 200, 500 y 1000 mg/L.
Para el día 4, las placas control y las tratadas con 10 mg/L de cipermetrina alcanzaron el diámetro máximo de las colonias fúngicas (8,5 cm). Las placas con 100 mg/L mostraron diámetros similares (8,2±0,02 cm), sin diferencias significativas en comparación con el control. Sin embargo, las placas tratadas con 200 mg/L presentaron un diámetro de 7,8±0,14 cm, significativamente menor que el control. Las concentraciones más altas (500, 1000 y 2000 mg/L) mostraron reducciones significativas en el diámetro de las colonias, con valores de 4,6±0,25 cm, 4,1±0,09 cm y 1,35±0,02 cm, respectivamente. En el día 7, las placas tratadas con 100 mg/L y 200 mg/L de cipermetrina alcanzaron diámetros máximos similares a las placas control, con valores de 8,5±0,00 cm y 8,4±0,16 cm, respectivamente (Figura 1). Las placas con concentraciones de 500 mg/L y 1000 mg/L presentaron diámetros de 7,8±0,66 cm y 7,6±0,31 cm, respectivamente. En este día, no se observaron diferencias significativas entre las concentraciones de 10, 100, 200, 500 y 1000 mg/L y el control. Por el contrario, las placas tratadas con 2000 mg/L mostraron una diferencia significativa en el crecimiento, con un diámetro de 1,9±0,47 cm.

Figura 1. Diámetros de colonias de Trichoderma asperelloides TF5 a diferentes concentraciones de cipermetrina en PDA tras 1, 4 y 7 días de crecimiento. Letras diferentes indican diferencias significativas según Tukey (α=0,05).
La Figura 2 presenta los porcentajes de inhibición del crecimiento fúngico en comparación con el control, bajo diferentes concentraciones de cipermetrina en los días 1, 4 y 7 de crecimiento.
En el día 1, los porcentajes de inhibición variaron entre el 19,3±1,01% y el 33,6±1,01% para las placas tratadas con concentraciones de cipermetrina de 10, 100, 200, 500 y 1000 mg/L. Mientras que las placas tratadas con 2000 mg/L mostraron una inhibición completa del crecimiento fúngico.
En el día 4, las placas tratadas con 10 mg/L no presentaron inhibición del crecimiento, alcanzando diámetros máximos equivalentes a los del control, lo que resultó en un porcentaje de inhibición del 0%. Los porcentajes de inhibición para las concentraciones de 100 y 200 mg/L fueron del 4,1±0,3% y 8,2±1,7%, respectivamente. Las concentraciones de 500 y 1000 mg/L mostraron inhibiciones más altas, con valores del 45,7±3,1% y 51,4±1,1%, respectivamente. La concentración más alta, 2000 mg/L, presentó un porcentaje de inhibición del 84,1±0,3%. En el día 7, no se observó inhibición en las placas tratadas con 10 y 100 mg/L, con porcentajes de inhibición del 0%. Para las concentraciones de 200, 500 y 1000 mg/L, los porcentajes de inhibición fueron del 1,4±1,94%, 8,2±7,76% y 11,2±3,6%, respectivamente. La concentración de 2000 mg/L mantuvo un alto nivel de inhibición con un porcentaje del 77,3±5,55%.
La Figura 4 muestra imágenes representativas del crecimiento de Trichoderma asperelloides en placas de Petri en el día 7 de incubación, bajo diferentes concentraciones de cipermetrina. Se observa claramente una reducción del crecimiento micelial a medida que aumenta la concentración del insecticida, siendo casi nulo el crecimiento a 2000mg/L.
Utilizando la ecuación derivada de la gráfica de regresión lineal que relaciona la concentración de cipermetrina con el porcentaje de inhibición (Figura 3), se estimó que la concentración de cipermetrina necesaria para inhibir el 50% del crecimiento fúngico es de aproximadamente 1150 mg/L.

Figura 2. Inhibición de crecimiento fúngico (%) a distintas concentraciones de cipermetrina en PDA. Letras diferentes indican diferencias significativas según Tukey (α=0,05).

Figura 3. Regresión lineal de la relación entre la concentración de cipermetrina y el porcentaje de inhibición de crecimiento fúngico de Trichoderma asperelloides TF5 en medio PDA.
Figura 4. Crecimiento micelial de T. asperelloides TF5 en PDA a diferentes concentraciones de cipermetrina en el Día 7. a) Control (0 mg/L) b) 10mg/L c) 100mg/L d) 200mg/L e) 500mg/L f) 1000mg/L g) 2000mg/L.
Discusión
Dentro del reino Fungi el género Trichoderma ha sido un importante foco de investigaciones, no solo por su potencial en el control de fitopatógenos sino también por su adaptabilidad a condiciones de cultivo estresantes o ambientes contaminados; diversos estudios han demostrado la capacidad de varias especies con capacidad de crecer en presencia de plaguicidas, lo que es crucial para que Trichoderma pueda ser utilizado eficazmente en ambientes agrícolas donde estos compuestos están presentes. Las especies más utilizadas para estos fines de investigación son T. harzanium, asperellum y virens (Mendarte-Alquisira et al., 2024).
El hongo Trichoderma exhibe tolerancia a insecticidas a través de diversos mecanismos. La adaptación inicial, evidenciada por el crecimiento micelial tras las primeras horas de exposición, es crucial (Andrade-Hoyos et al., 2023). La detoxificación se lleva a cabo mediante mecanismos moleculares de producción de enzimas que son capaces de descomponer un insecticida en compuestos menos tóxicos, como la actividad de la peroxidasa. También se ha propuesto la actividad de la quitinasa como biomarcador de procesos de desintoxicación en sistemas contaminados con insecticidas. La biotransformación, otra capacidad enzimática, consiste en la utilización de los insecticidas como fuente de carbono y energía (Mendarte-Alquisira et al., 2024).
La tolerancia a los agroquímicos varía entre especies e incluso cepas de Trichoderma; la comprensión de los mecanismos de tolerancia se vuelve imprescindible para ayudar a desarrollar cepas con resistencia a agroquímicos específicos (Andrade-Hoyos et al., 2023).
Sabogal-Vargas et al. (2023), evaluaron el crecimiento de T. asperellum e identificaron crecimiento micelial en cultivos con diferentes concentraciones del insecticida organofosforado Clorpirifos® de uso agrícola. El estudio incluyó la evaluación simultánea de su capacidad antagonista contra Botrytis sp. en cultivos duales, y no fueron observados efectos significativos en esta capacidad en comparación con los controles.
Otras especies reportadas son T. koningii, T. virens y T. atroviride, las cuales demostraron la tolerancia en medio sólido a concentraciones de 200 ppm del insecticida H24®, compuesto por piretroides incluyendo permetrina como uno de los ingredientes activos (Mendarte-Alquisira et al., 2024).
Sin embargo, los reportes sobre la especie Trichoderma asperelloides y su tolerancia a insecticidas han sido muy limitados. Chaparro et al. (2011), han reportado tres cepas de T. asperelloides que fueron capaces de crecer y esporular en medios conteniendo un 75% de las dosis recomendadas para aplicación en campo de combinaciones de fungicidas químicos.
En este estudio se demostró que, la cepa TF5 de Trichoderma asperelloides, tras siete días de tratamiento, no presentó diferencias significativas en el crecimiento micelial en comparación con el control, incluso a concentraciones de cipermetrina de hasta 1000 mg/L (Figura 1), lo que indica una potencial capacidad de tolerancia natural al insecticida.
La tolerancia de Trichoderma a agroquímicos y otros contaminantes lo convierte en un candidato prometedor para la biorremediación de suelos y aguas contaminadas. Ríos et al., 2019., han demostrado la capacidad de T. asperellum de crecer utilizando como única fuente de carbono al insecticida cipermetrina, indicando que hubo una síntesis de biomoléculas a partir de macroelementos tomados del medio y del insecticida.
El uso de cepas nativas de hongos en la biorremediación presenta ventajas importantes, ya que al estar adaptados a las condiciones locales, pueden degradar contaminantes de manera más eficiente y minimizar riesgos ecológicos asociados a la introducción de especies foráneas. Además, la amplia diversidad enzimática de estos hongos favorece la transformación de compuestos tóxicos en sustancias menos dañinas, haciendo que el proceso sea más sostenible (Pointing, 2001; Harms et al., 2011).
La tolerancia mencionada anteriormente no se observó en el tratamiento con una concentración de 2000 mg/L, donde el crecimiento micelial fue muy limitado. Este tratamiento resultó en un porcentaje de inhibición del crecimiento del 77% al final del ensayo (Figura 2). En estudios previos, se han reportado porcentajes de inhibición similares con T. harzianum, con un 66% de inhibición utilizando 2000 mg/L de cipermetrina (Castellanos González et al., 2015).
La compatibilidad de ciertas especies de Trichoderma con fungicidas específicos permite combinar ambos enfoques, reduciendo potencialmente la dependencia de químicos y mejorando la sostenibilidad del control de enfermedades. Terrero Yépez et al. (2018), analizaron la compatibilidad de cuatro especies de Trichoderma con fungicidas utilizados en cacao.
El estudio mostró buena compatibilidad de T. ovalisporum con el fungicida químico Azoxistrobina (Bankit®) en dosis altas y bajas, lo que indica que el hongo posee mecanismos moleculares para coexistir y potencialmente mantener su eficacia como agente de control biológico en ambientes con la presencia de este químico (Terrero Yépez et al., 2018).
En el presente estudio, la concentración de cipermetrina necesaria para inhibir el 50% del crecimiento micelial de Trichoderma asperelloides TF5 se estimó en 1150 mg/L mediante un modelo de regresión lineal, con un coeficiente de determinación de 0.95 (Figura 3). Este resultado es comparable con el obtenido por Castellanos González et al. (2015), quienes reportaron una inhibición del 47.7% en el crecimiento de T. asperellum a una concentración de 1000 mg/L de cipermetrina. Ambos estudios sugieren una eficacia similar de la cipermetrina para inhibir el crecimiento micelial en diferentes especies.
El valor resultante puede considerarse relativamente elevado teniendo en cuenta las concentraciones recomendadas en campo que, si bien varían dependiendo del cultivo y de las plagas que se requieran tratar, para cultivos hortícolas es de 100 mg/L (Castellanos González et al., 2015), y las recomendaciones del fabricante del insecticida utilizado en este estudio varía de 100-1000 mg/L. Por lo que se espera que la cepa TF5 de Trichoderma asperelloides, utilizada en este estudio, sea capaz de tolerar las concentraciones de cipermetrina de uso a campo para control integrado de plagas.
Conclusiones
Los resultados presentados en este estudio demostraron que la cepa TF5 de Trichoderma asperelloides ha evidenciado tolerancia a concentraciones altas de cipermetrina, estimando una inhibición del 50% de crecimiento micelial a una concentración de 1150mg/L de cipermetrina, siendo esta concentración comparable a la utilizada regularmente en campo. La capacidad de esta cepa de tolerar niveles elevados del insecticida abre posibilidades para su aplicación en la descontaminación de suelos y ecosistemas afectados por este compuesto químico. La utilización de la cepa TF5 de Trichoderma asperelloides podría contribuir a mitigar los efectos nocivos de la cipermetrina en el medio ambiente.
Agradecimientos: Deseamos expresar nuestro agradecimiento a la Dra. Andrea Arrua, Líder de Mycology Investigation and Safety Team, por proveer la cepa utilizada en este estudio. Su apoyo y generosidad han sido fundamentales para el desarrollo de este trabajo. También queremos agradecer al Msc. Shaun McGahan por su ayuda y colaboración durante el proceso experimental.
Contribución de los autores: Conceptualización: G.G.D., R.N.C., N.S.R., J.P.S., A.F.G., A.O.M. Curación de datos: G.G.D., R.N.C., G.A.B Análisis formal: G.G.D., R.N.C., G.A.B Adquisición de fondos:G.G.D., R.N.C., N.S.R., J.P.S., A.F.G., A.O.M. Investigación: G.G.D., R.N.C. Metodología:G.G.D., R.N.C., N.S.R. Administración del proyecto: C.D.A.R.; Recursos: G.G.D., R.N.C., N.S.R., J.P.S., A.F.G., A.O.M. Software; G.G.D., G.A.B. Supervisión: G.A.B. Validación: G.G.D., G.A.B. Visualización: G.G.D. Redacción – borrador original: G.G.D., R.N.C. Redacción – revisión y edición: G.G.D., R.N.C.
Fuente de Financiamiento: Esta investigación no recibió financiamiento externo.
Disponibilidad de datos: Los datos utilizados en esta investigación podrán ser solicitados al autor de correspondencia según pertinencia.
Referencias Bibliográficas
Andrade-Hoyos, P., Rivera-Jiménez, M. N., Landero-Valenzuela, N., Silva-Rojas, H. V., Martínez-Salgado, S. J., y Romero-Arenas, O. (2023). Beneficios ecológicos y biológicos del hongo cosmopolita Trichoderma spp. en la agricultura: Una perspectiva en el campo mexicano. Revista Argentina de Microbiología, 55(4), 366–377. https://doi.org/10.1016/j.ram.2023.06.005
Castellanos González, L., Lorenzo Nicao, M. E., Muiño, B. L., Hernández Pérez, R., y Guillen Sánchez, D. (2015). Efecto in vitro de plaguicidas comerciales sobre Trichoderma harzianum cepa A-34. Revista de la Facultad de Ciencias Agrarias, 47(2), 185-196.
Cámara Paraguaya de Exportadores y Oleaginosas (CAPECO) (2024). El sector agrícola verificó un incremento del 23,3% al cierre del año 2023. https://capeco.org.py/2024/04/01/el-sector-agricola-verifico-un-incremento-del-233-al-cierre-del-ano-2023/
Chaparro, A. P., Carvajal, L. H., y Orduz, S. (2011). Fungicide tolerance of Trichoderma asperelloides and T. harzianum strains. Agricultural sciences, 2(03), 301. doi:10.4236/as.2011.23040
Chen, S., Hu, Q., Hu, M., Luo, J., Weng, Q., y Lai, K. (2011). Isolation and characterization of a fungus able to degrade pyrethroids and 3-phenoxybenzaldehyde. Bioresource technology, 102(17), 8110–8116. https://doi.org/10.1016/j.biortech.2011.06.055
Gajendiran, A. y Abraham, J. (2018). Una descripción general de los insecticidas piretroides. Frontiers in Biology, 13 , 79-90. https://doi.org/10.1007/s11515-018-1489-z
Harms, H., Schlosser, D. y Wick, L. Y. (2011). Untapped potential: exploiting fungi in bioremediation of hazardous chemicals. Nature Reviews Microbiology,9(3), 177-192. https://doi.org/10.1038/nrmicro2519
Hernández-Melchor, D. J., Ferrera-Cerrato, R., y Alarcón, A. (2019). Trichoderma: importancia agrícola, biotecnológica, y sistemas de fermentación para producir biomasa y enzimas de interés industrial. Chilean journal of agricultural & animal sciences, 35(1), 98-112. http://dx.doi.org/10.4067/S0719-38902019005000205
Kaur, R., & Singh, J. (2021). Toxicity, monitoring, and biodegradation of cypermethrin insecticide: A review. Nature, environment and pollution technology, 20(5). https://doi.org/10.46488/NEPT.2021.v20i05.016
Lin, Q. S., Chen, S. H., Hu, M. Y. Hag, M. U., Yang, L. y Li, H. (2011). Biodegradation of cypermethin by a newly isolated actinomycetes HU-S-01 from wastewater sludge. International Journal of Environmenta/ Science & Technology, 8(1), 45-56. doi.org/10.1007/BF03326194
López Arias, T. R., Esquivel Mattos, A., y Peris, S. (2021). Evaluación ecotoxicológica de arroyos de la reserva San Rafael y su zona de amortiguamiento mediante bioensayos con Daphnia magna y Lactuca sativa. Steviana, 7, 102–115. https://doi.org/10.56152/StevianaFacenV7A9_2015
Maqbool, Z., Hussain, S., Imran, M., Mahmood, F., Shahzad, T., Ahmed, Z., y Muzammil, S. (2016). Perspectives of using fungi as bioresource for bioremediation of pesticides in the environment: a critical review. Environmental Science and Pollution Research International, 23(17), 16904–16925. https://doi.org/10.1007/s11356-016-7003-8
Mendarte-Alquisira, C., Alarcón, A., y Ferrera-Cerrato, R. (2024). Growth, tolerance, and enzyme activities of Trichoderma strains in culture media added with a pyrethroids-based insecticide. Revista Argentina de Microbiología, 56(1), 79-89. https://doi.org/10.1016/j.ram.2023.06.004
Odukkathil, G., y Vasudevan, N. (2013). Toxicity and bioremediation of pesticides in agricultural soil. Re/Views in Environmental Science and Bio/Technology, 12(4), 421–444. https://doi.org/10.1007/s11157-013-9320-4
Pointing, S. (2001). Feasibility of bioremediation by white-rot fungi. Applied microbiology and biotechnology, 57, 20-33. https://doi.org/10.1007/s002530100745
Ríos, M. Á. M., Villacorta, W. A. R., y Ramos, I. L. M. (2019). Crecimiento de Trichoderma asperellum en medio sólido utilizando como única fuente de carbono a los plaguicidas clorpirifos y cipermetrina. UCV-SCIENTIA, 11(2), 149-156.
Sabogal-Vargas, A. M., Wilson-Krugg, J., Rojas-Villacorta, W., De La Cruz-Noriega, M., Otiniano, N. M., Rojas-Flores, S., y Mendoza-Villanueva, K. (2023). In vitro compatibility of three native isolates of Trichoderma with the insecticide chlorpyrifos. Applied Sciences, 13(2), 811. https://doi.org/10.3390/app13020811
Terrero Yépez, P. I., Peñaherrera Villafuerte, S. L., Solís Hidalgo, Z. K., Vera Coello, D. I., Navarrete Cedeño, J. B., y Herrera Defaz, M. A.. (2018). Compatibilidad in vitro de Trichoderma spp. con fungicidas de uso común en cacao (Theobroma cacao L.). Investigación Agraria, 20(2), 146-151. https://doi.org/10.18004/investig.agrar.2018.diciembre.146-151
Tripathi, P., Singh, P.C., Mishra, A. y Chauhan, P. S. (2013). Trichoderma : un biorremediador potencial para la limpieza ambiental. Clean Technologies and Environ Policy, 15 , 541–550. https://doi.org/10.1007/s10098-012-0553-7